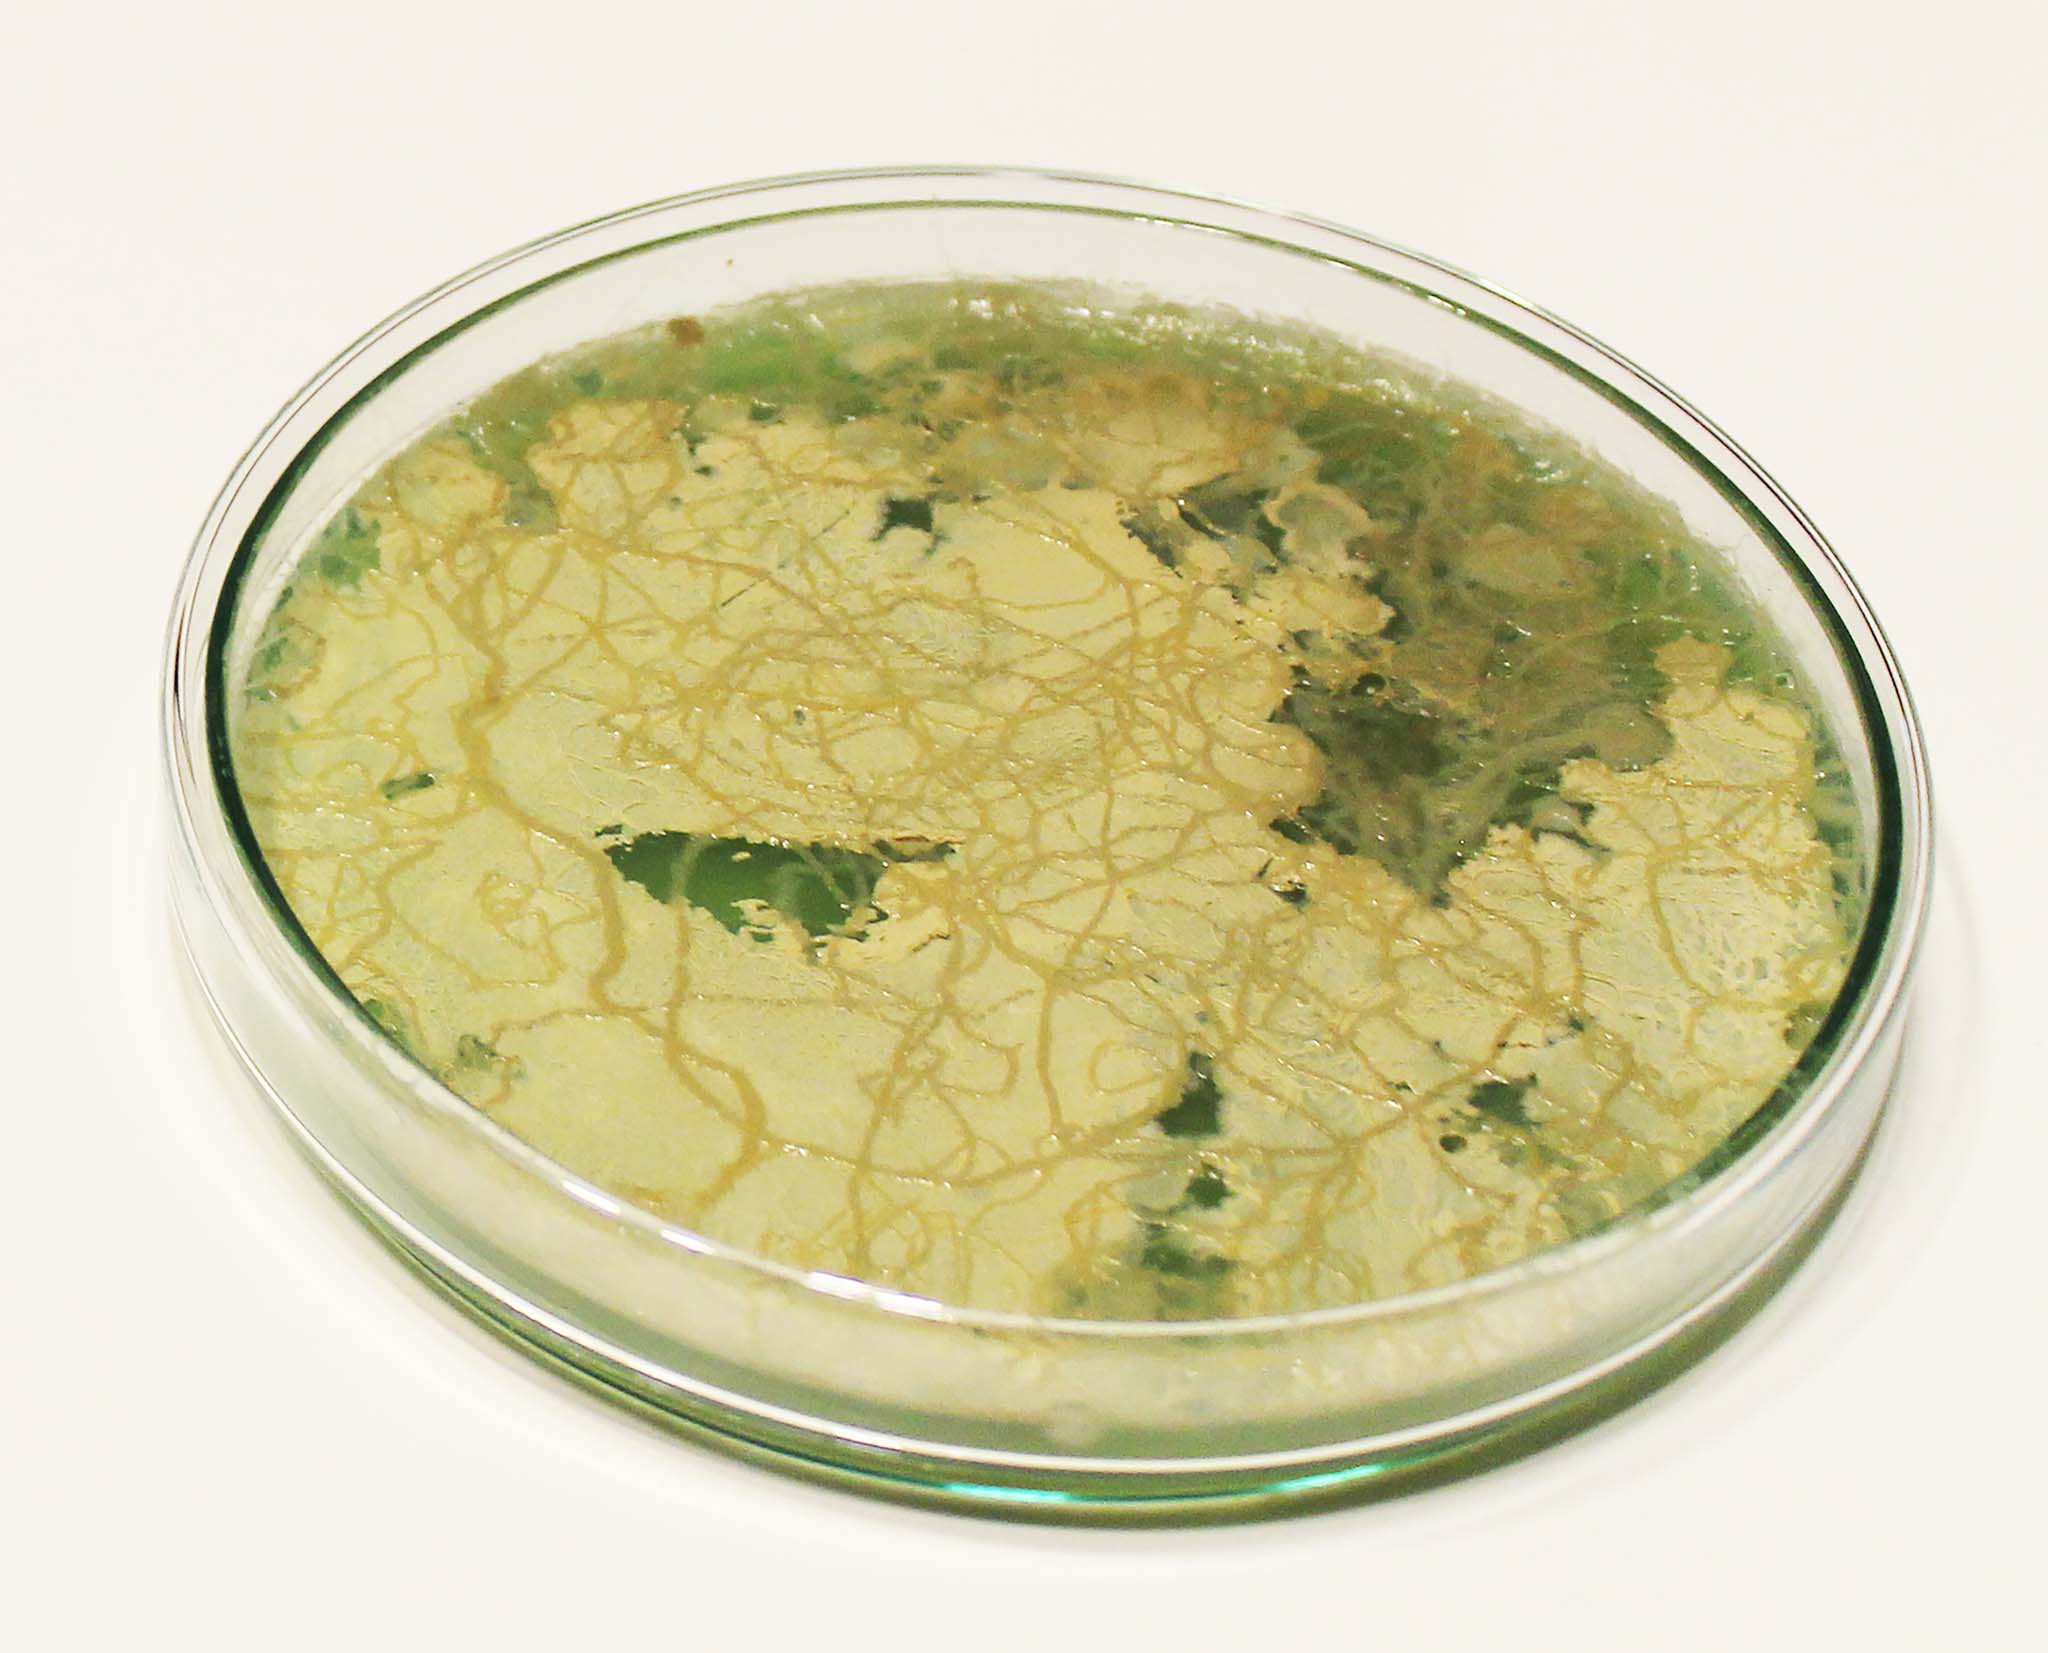

ANTIBODY
Die somatische Hypermutation beschreibt den Vorgang der Ausreifung der Antikörper unseres Immunssystems, die Idee ist eine möglichst breite Variation an Antikörpern zu haben um für jeden Virus den passenden Antikörper zu haben. Dieses Konzept habe ich auf den Menschen übertragen, ich benutze den menschlichen Körper als den KÖRPER und verschiedene Stühle als ANTIKÖRPER. So soll auch jeder KÖRPER seinen passenden ANTIKÖRPER haben. Eine weitere Muation findet in dem Halbzeug statt, als Kategorie für Stühle habe ich mir Freischwinger ausgesucht, die normalerweise aus Rohren bestehen. Die Idee war es weg zu kommen von den Rohren und hin zum Metallblech. Durch Sicken im Stahlblech konnte ich das Blech versteifen und anschließend in Form bringen. Als Prototypen habe ich einen meiner drei entworfenen Stühle gebaut. Aus einem 1650mm x 460mm x 2mm Stahlblech wurde der ANTIKÖRPER-1 geformt. Mithilfe von vier Matrizen und zwei Pressen konnte ich das Blech verformen, so wie ich es Entworfen hatte. Der Prototyp war auch ein Experiment, teils hat es die Erwartungen erfüllt, teils auch nicht, durch ein paar Ungenauigkeiten hält der Stuhl nur kleinere und leichtere Personen aus. Das ist aber auch in Ordnung, weil die ANTIKÖRPER ja auch immer nur auf einen KÖRPER gut passen.
Somatic hypermutation describes the process of maturation of the antibodies of our immune system, the idea is to have the widest possible variation of antibodies to have the appropriate antibody for each virus. I have transferred this concept to humans, I use the human body as the BODY and different stools as the ANTIBODY. So also every BODY should have its matching ANTIBODY. Another muation takes place in the semi-finished product, as a category for chairs I have chosen cantilever chairs, which are usually made of tubes. The idea was to get away from the tubes and towards the metal sheet. By beading the sheet steel, I was able to stiffen the sheet and then shape it. As a prototype, I built one of my three designed chairs. The ANTIBODY-1 was formed from a 1650mm x 460mm x 2mm steel sheet. With the help of four dies and two presses I was able to form the sheet metal as I designed it. The prototype was also an experiment, partly it met the expectations, partly not, due to some inaccuracies the chair can only support smaller and lighter persons. But that’s okay, because the ANTIBODIES always fit well only on one BODY.
Prozess


































































































 process:
process:

















































































































































































































































































 More on PowerPlace by Philipp Hainke at
More on PowerPlace by Philipp Hainke at  More to Trunk by Aleksander Łuczak at
More to Trunk by Aleksander Łuczak at 







































































































































































































































































































 photo: Sander Plug
photo: Sander Plug